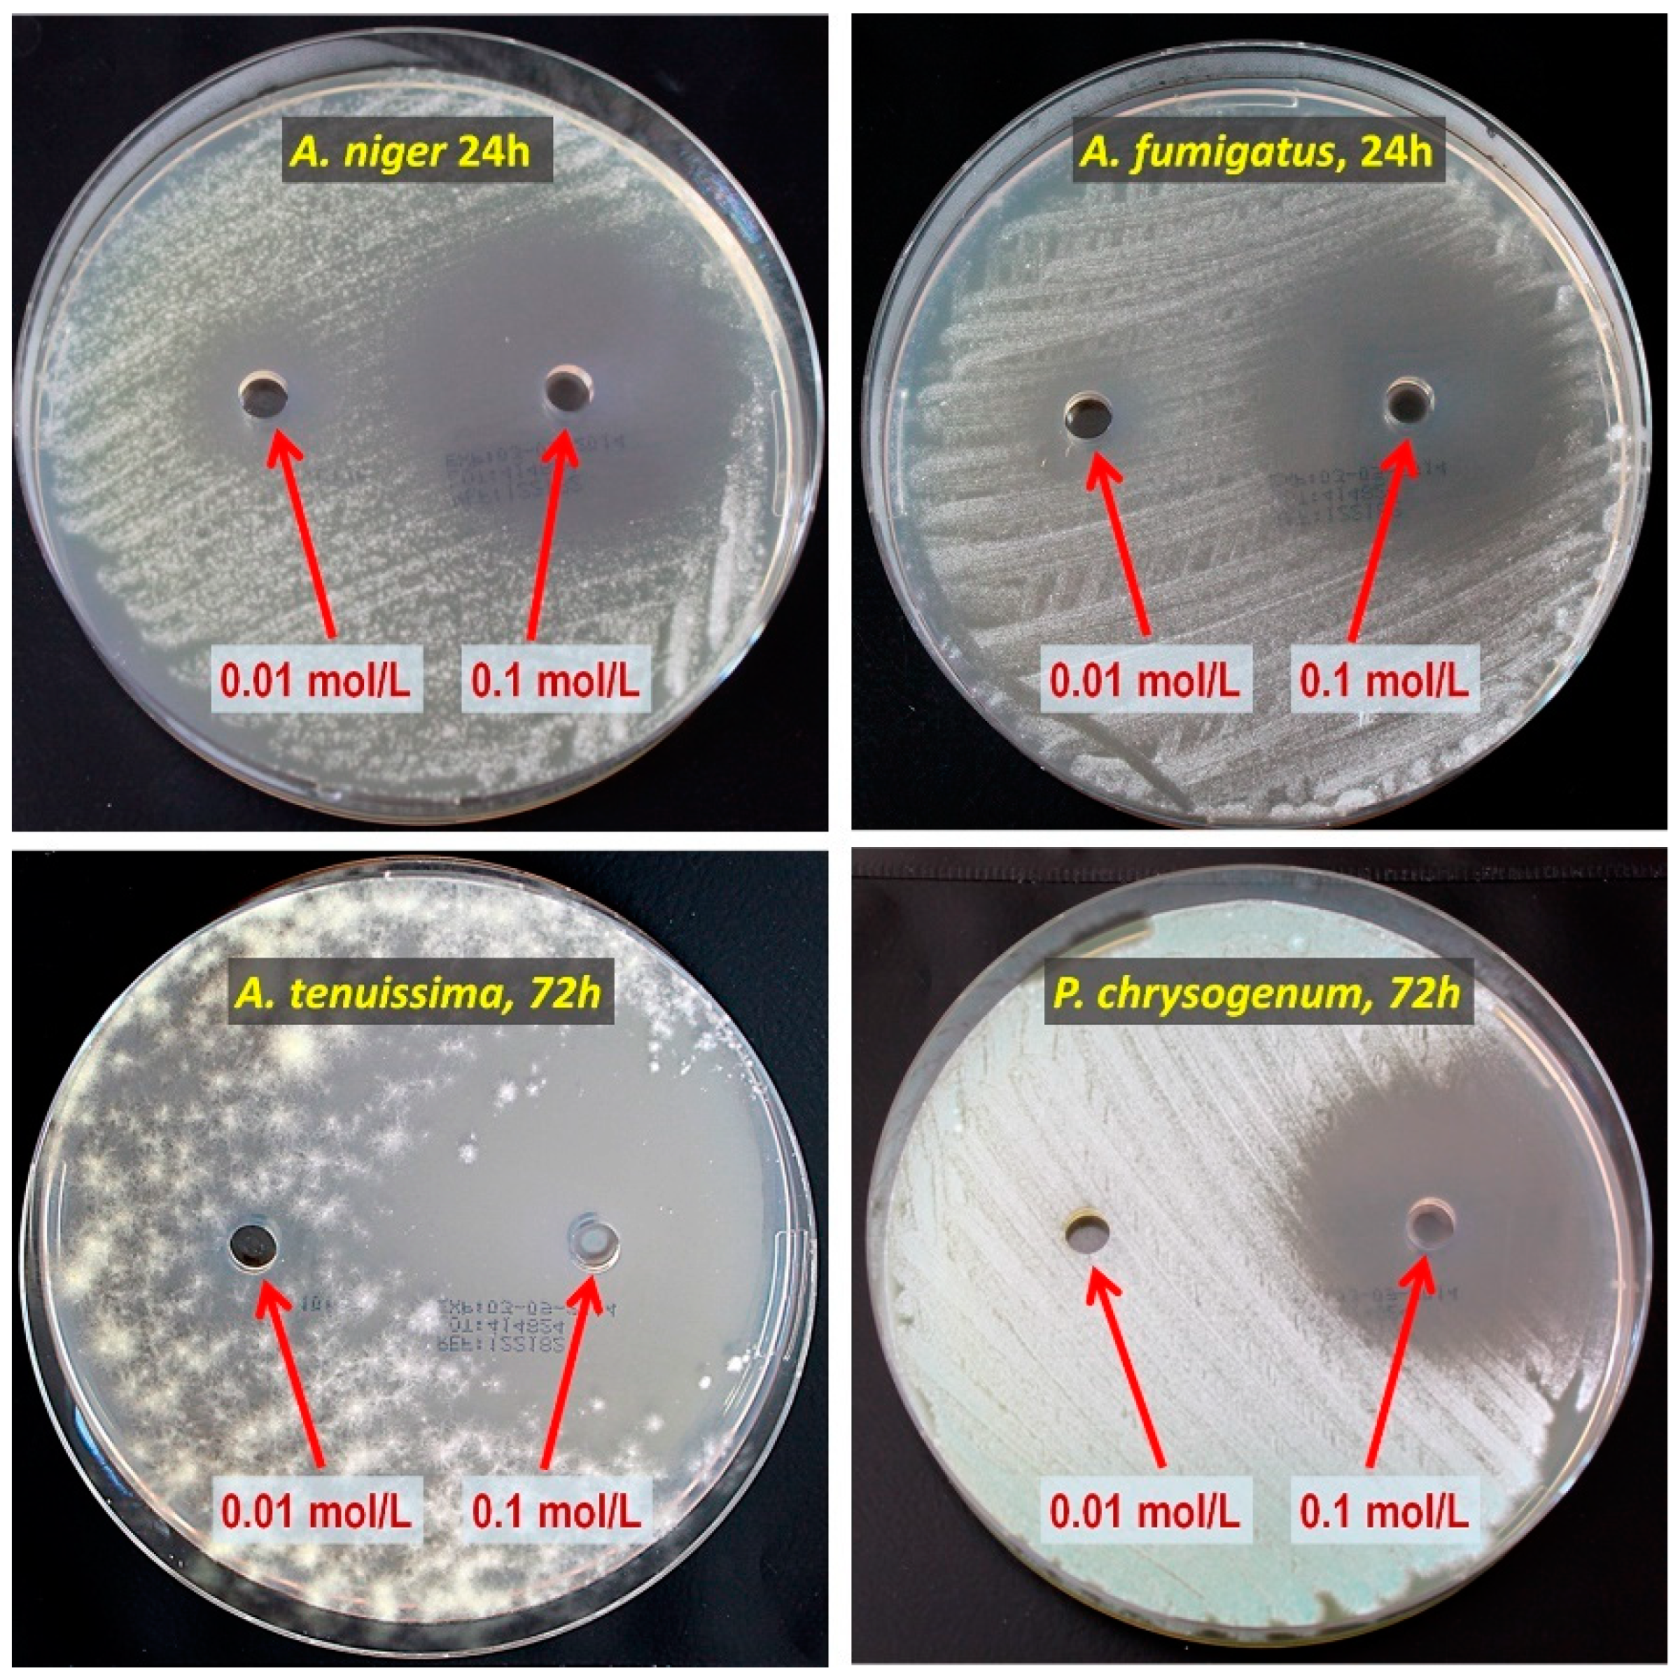
Materials 15 06834 g002

Anti-Mold Protection of Textile Surfaces with Cold Plasma Produced Biocidal Nanocoatings
Abstract
1. Introduction
2. Materials and Methods
2.1. Textile Fabrics
2.2. Mold Fungi
2.3. Antifungal Nanocoating Precursors
2.4. Preparation of Antifungal Nanocoatings
2.5. Characteristics of Nanocoatings
2.6. Microbiological Testing
- 0—No visible growth under the microscope (50×);
- 1—No visible growth to the naked eye, but clearly visible under the microscope;
- 2—Visible growth to the naked eye, coverage ≤ 25% of the area;
- 3—Visible growth to the naked eye, coverage ≤ 50% of the area;
- 4—Extensive growth, coverage > 50% of the area.
3. Results and Discussion
3.1. Antifungal Activity of Precursors
3.2. Structure of Nanocoatings
3.3. Antifungal Activity of Nanocoatings on Textiles
| M-0 | – | Textiles without any antifungal nanocoatings; |
| M-DMAA | – | The nanocoating prepared by plasma-activated grafting of N,N-dimethylallylamine (plasma activation: Ar, 40 W, 120 s; grafting: saturated vapor of 22.8 kPa, 15 min); |
| M-AA+DCP | – | Nanocoating prepared by plasma-activated grafting of allylamine (plasma activation: Ar, 40 W, 120 s; grafting: saturated vapor of 32.3 kPa, 2 h), and then anchoring 3,5-dichlorophenol (Section 2.4); |
| M-AA+TCS | – | Nanocoating prepared by plasma-activated grafting of allylamine (plasma activation: Ar, 40 W, 120 s; grafting: saturated vapor of 32.3 kPa, 2 h), and then anchoring triclosan (Section 2.4); |
| M-APh | – | Nanocoating prepared by plasma polymerization of 2-allylphenol (plasma activation: Ar, 40 W, 120 s; plasma polymerization: mixture of Ar and 2-allylphenol with flow rates of 1.0 and 0.3 sccm, respectively, 8.0 Pa, 5 W, 120 °C, 2 min). |
4. Conclusions
Author Contributions
Funding
Institutional Review Board Statement
Informed Consent Statement
Data Availability Statement
Acknowledgments
Conflicts of Interest
References
- Takai, K.; Ohtsuka, T.; Senda, Y.; Nakao, M.; Yamamoto, K.; Matsuoka, J.; Hirai, Y. Antibacterial properties of antimicrobial-finished textile products. Microbiol. Immunol. 2002, 46, 75–81. [Google Scholar] [CrossRef] [PubMed]
- Dastjerdi, R.; Montazer, M. A review on the application of inorganic nano-structured materials in the modification of textiles: Focus on anti-microbial properties. Colloid Surf. B-Biointerfaces 2010, 79, 5–18. [Google Scholar] [CrossRef] [PubMed]
- Morais, D.S.; Guedes, R.M.; Lopes, M.A. Antimicrobial approaches for textiles: From research to market. Materials 2016, 9, 498. [Google Scholar] [CrossRef]
- Mondal, I.H. (Ed.) Antimicrobial Textiles from Natural Resources; Woodhead Publishing: Duxford, UK, 2021. [Google Scholar]
- Lishchynskyi, O.; Shymborska, Y.; Stetsyshyn, Y.; Raczkowska, J.; Skirtach, A.G.; Peretiatko, T.; Budkowski, A. Passive antifouling and active self-disinfecting antiviral surfaces. Chem. Eng. J. 2022, 446, 137048. [Google Scholar] [CrossRef] [PubMed]
- Walentowska, J.; Foksowicz-Florczyk, J. Thyme essential oil for antimicrobial protection of natural textiles. Int. Biodeterior. Biodegrad. 2013, 84, 407–411. [Google Scholar] [CrossRef]
- Havrlik, M.; Ryparová, P. Protection of wooden materials against biological attack by using nanotechnology. Acta Polytech. 2015, 55, 101–108. [Google Scholar] [CrossRef]
- Chapman, J.S. Biocide resistance mechanisms. Int. Biodeterior. Biodegrad. 2003, 51, 133–138. [Google Scholar] [CrossRef]
- Ibrahim, A.; Laquerre, J.; Forcier, P.; Deregnaucourt, V.; Decaens, J.; Vermeersch, O. Antimicrobial agents for textiles: Types, mechanisms and analysis standards. In Textiles for Functional Applications; Kumar, B., Ed.; IntechOpen: London, UK, 2021. [Google Scholar] [CrossRef]
- Finley, J.A.; Callow, M.E. The potential of alkyl amines as antifouling biocides, I: Toxicity and structure activity relationships. Biofouling 1996, 9, 257–268. [Google Scholar] [CrossRef]
- Gulati, R.; Sharma, S.; Sharma, R.K. Antimicrobial textile: Recent developments and functional perspective. Polym. Bull. 2022, 79, 5747–5771. [Google Scholar] [CrossRef]
- Ferreira, L.; Zumbuehl, A. Non-leaching surfaces capable of killing microorganisms on contact. J. Mater. Chem. 2009, 19, 7796–7806. [Google Scholar] [CrossRef]
- Ye, Y.; Song, Q.; Mao, Y. Single-step fabrication of non-leaching antibacterial surfaces using vapor crosslinking. J. Mater. Chem. 2011, 21, 257–262. [Google Scholar] [CrossRef]
- Zahran, M.K.; Ahmed, H.B.; El-Rafie, M.H. Surface modification of cotton fabrics for antibacterial application bycoating with AgNPs–alginate composite. Carbohydr. Polym. 2014, 108, 145–152. [Google Scholar] [CrossRef]
- Xu, Q.B.; Xie, L.J.; Diao, H.; Li, F.; Zhang, Y.Y.; Fu, F.Y.; Lui, X.D. Antibacterial cotton fabric with enhanced durability prepared using silver nanoparticles and carboxymethyl chitosan. Carbohydr. Polym. 2017, 177, 187–193. [Google Scholar] [CrossRef]
- Xu, Q.B.; Zheng, W.S.; Duan, P.P.; Chen, J.N.; Zhang, Y.Y.; Fu, F.Y.; Diao, H.Y.; Lui, X.D. One-pot fabrication of durable antibacterial cotton fabric coated with silver nanoparticles via carboxymethyl chitosan as a binder and stabilizer. Carbohydr. Polym. 2019, 204, 42–49. [Google Scholar] [CrossRef] [PubMed]
- Periyasamy, A.P.; Venkataraman, M.; Kremenakova, D.; Militky, J.; Zhou, Y. Progress in sol-gel technology for the coatings of fabrics. Materials 2020, 13, 1838. [Google Scholar] [CrossRef] [PubMed]
- Nedĕla, O.; Slepička, P.; Švorčik, V. Surface modification of polymer substrates for biomedical applications. Materials 2017, 10, 1115. [Google Scholar] [CrossRef] [PubMed]
- Naebe, M.; Haque, A.N.M.A.; Haji, A. Plasma-assisted antimicrobial finishing of textiles: A review. Engineering 2022, 12, 145–163. [Google Scholar] [CrossRef]
- Inagaki, N. Plasma Surface Modification and Plasma Polymerization; Technomic Publishing: Lancaster, PA, USA, 1996. [Google Scholar]
- Mráček, A.; Lehocký, M.; Smolka, P.; Grulich, O.; Velebný, V. The allylamine grafting on the plasma pre-treated polyester nonwoven fabric: Preparation, characterization and utilization. Fiber. Polym. 2010, 11, 1106–1110. [Google Scholar] [CrossRef][Green Version]
- Bilek, F.; Křižová, T.; Lehocký, M. Preparation of active antibacterial LDPE surface through multistep physicochemical approach: I. Allylamine grafting, attachment of antibacterial agent and antibacterial activity assessment. Colloid Surf. B-Biointerfaces 2011, 88, 440–447. [Google Scholar] [CrossRef] [PubMed]
- Bilek, F.; Sulovská, K.; Lehocký, M.; Sáha, P.; Humpoliček, P.; Mozetič, M.; Junkar, I. Preparation of active antibacterial LDPE surface through multistep physicochemical approach II: Graft type effect on antibacterial properties. Colloid Surf. B-Biointerfaces 2013, 102, 842–848. [Google Scholar] [CrossRef]
- Aumsuwan, N.; Heinnhorst, S.; Urban, M.W. Antibacterial surfaces on expanded polytetrafluoroethylene; penicillin attachment. Biomacromolecules 2007, 8, 713–718. [Google Scholar] [CrossRef] [PubMed]
- Aumsuwan, N.; McConnell, M.S.; Urban, M.W. Tunable antimicrobial polypropylene surfaces: Simultaneous attachment of penicillin (gram +) and gentamicin (gram −). Biomacromolecules 2009, 10, 623–629. [Google Scholar] [CrossRef]
- Haji, A.; Mehrizi, M.K.; Akbarpour, R. Optimization of β-cyclodextrin grafting on wool fibers improved by plasma treatment and assessment of antibacterial activity of berberine finished fabric. J. Incl. Phenom. Macrocycl. Chem. 2015, 81, 121–133. [Google Scholar] [CrossRef]
- Malshe, P.; Mazloumpour, M.; El-Shafei, A.; Hauser, P. Functional military textile: Plasma-induced graft polymerization of DADMAC for antimicrobial treatment on nylon-cotton blend fabric. Plasma Chem. Plasma Process. 2012, 32, 833–843. [Google Scholar] [CrossRef]
- Widodo, M.; El-Shafei, A.; Hauser, P.J. Surface nanostructuring of Kevlar fibers by atmospheric pressure plasma-induced graft polymerization for multifunctional protective clothing. J. Polym. Sci. Pol. Phys. 2012, 50, 1165–1172. [Google Scholar] [CrossRef]
- Malzahn, K.; Duque, L.; Ciernak, P.; Wiesenmüller, S.; Bender, K.; Förch, R. Antimicrobial activity and cyto-compatibility of plasma polymerized zinc acetylacetonate thin films. Plasma Process. Polym. 2013, 10, 243–249. [Google Scholar] [CrossRef]
- Hegemann, D.; Hossain, M.M.; Balazs, D.J. Nanostructured plasma coatings to obtain multifunctional textile surfaces. Prog. Org. Coat. 2007, 58, 237–240. [Google Scholar] [CrossRef]
- Juknius, T.; Ružauskas, M.; Tamulevičius, T.; Šiugždinienė, R.; Juknienė, I.; Vasiliaukas, A.; Jurkevičiūtė, A.; Tamulevičius, S. Antimicrobial properties of diamond-like carbon/silver nanocomposite thin films deposited on textiles: Towards smart bandages. Materials 2016, 9, 371. [Google Scholar] [CrossRef]
- Brunon, C.; Chadeau, E.; Oulahal, N.; Grossiord, C.; Dubost, L.; Simon, F.; Bessueille, F.; Degraeve, P.; Leonard, D. Antimicrobial finishing of textiles intended for food processing industry by plasma enhanced chemical vapor deposition—Physical vapor deposition of Ag-SiOCH composites coated with AlxOy or SiOCH encapsulation layers. Thin Solid Films 2017, 628, 132–141. [Google Scholar] [CrossRef]
- Twardowski, A.; Makowski, P.; Małachowski, A.; Hrynyk, R.; Pietrowski, P.; Tyczkowski, J. Plasma Treatment of Thermoactive Membrane Textiles for Superhydrophobicity. Mater. Sci.-Medzg. 2012, 18, 163–166. [Google Scholar] [CrossRef]
- Tyczkowski, J.; Makowski, P.; Twardowski, A.; Małachowski, A.; Pietrowski, P.; Hrynyk, R. Method for Producing Superhydrophobic Nanostructures on the Surface of Textile Materials, with the Use of Plasma. Patent PL 220651, 30 November 2015. [Google Scholar]
- Kapica, R.; Markiewicz, J.; Tyczkowska-Sieroń, E.; Fronczak, M.; Balcerzak, J.; Sielski, J.; Tyczkowski, J. Artificial superhydrophobic and antifungal surface on goose down by cold plasma treatment. Coatings 2020, 10, 904. [Google Scholar] [CrossRef]
- Tyczkowski, J.; Kapica, R.; Markiewicz, J.; Małachowski, A.; Małachowski, B. Method for Producing Durable Water-Repellent Layer on the Surface of Natural Down. Patent PL 228924, 19 December 2017. [Google Scholar]
- McDonnell, G.; Russell, D. Antiseptics and disinfectants: Activity, action, and resistance. Clin. Microbiol. Rev. 1999, 12, 147–179. [Google Scholar] [CrossRef] [PubMed]
- Timofeeva, L.; Kleshcheva, N. Antimicrobial polymers: Mechanism of action, factors of activity, and applications. Appl. Microbiol. Biotechnol. 2011, 89, 475–492. [Google Scholar] [CrossRef] [PubMed]
- Tyczkowski, J.; Kierzkowska-Pawlak, H.; Kapica, R.; Balcerzak, J.; Sielski, J. Cold plasma—A promising tool for the production of thin-film nanocatalysts. Catal. Today 2019, 337, 44–54. [Google Scholar] [CrossRef]
- PN EN 14119:2005; Testing of Textiles—Evaluation of the Action of Microfungi. Polish Committee for Standardization Publishing: Warsaw, Poland, 2013.
- Coates, J. Interpretation of infrared spectra, a practical approach. In Encyclopedia of Analytical Chemistry; Meyers, R.A., Ed.; John Wiley & Sons Ltd.: Chichester, UK, 2000. [Google Scholar]
- Nandiyanto, A.B.D.; Oktiani, R.; Ragadhita, R. How to read and interpret FTIR spectroscope of organic material. IJoST 2019, 4, 97–118. [Google Scholar] [CrossRef]
- Shi, L.S.; Wang, L.Y.; Wang, Y.N. The investigation of argon plasma surface modification to polyethylene: Quantitative ATR-FTIR spectroscopic analysis. Eur. Polym. J. 2006, 42, 1625–1633. [Google Scholar] [CrossRef]
- Tyczkowski, J.; Kierzkowska-Pawlak, H.; Sielski, J.; Krawczyk-Kłys, I. Low-temperature plasma modification of styrene–butadiene block copolymer surfaces for improved adhesion—A kinetic approach. Polymers 2020, 12, 935. [Google Scholar] [CrossRef]
- John Wiley & Sons, Inc. SpectraBase. 2-Allylphenol. Available online: https://spectrabase.com/spectrum/DB1DQpcgs1w (accessed on 25 July 2022).
- Tyczkowski, J.; Kapica, R.; Markiewicz, J.; Tyczkowska-Sieroń, E.; Kiryszewska, A.; Małachowski, A.; Małachowski, B. Method for Producing Antifungal Nanolayer on the Surface of Textile Materials, with the Use of Plasma. Patent PL 232780, 22 March 2019. [Google Scholar]

| Textile | Type of Material |
|---|---|
| T1 | Micro Rip-Stop 100% polyester (both sides) |
| T2 | Micro Rip-Stop inner side—100% polyester outer side—100% polyurethane |
| T3 | 100% natural cotton (both sides) grammage 165 g/m2 |
| T4 | Micro Rip-Stop inner side—100% nylon outer side—100% silicon |
| Precursor | Formula | Characteristic |
|---|---|---|
| Phenols | ||
| 2-Allylphenol (APh) |  | liquid assay 98% b.p. 220 °C |
| 2-Methoxy-4-(2-propenyl)phenol (Eugenol) |  | liquid assay 99% b.p. 254 °C |
| Amines | ||
| Allylamine (AA) |  | liquid assay 98% b.p. 53 °C |
| N,N-Dimethylallylamine (DMAA) |  | liquid assay ≥ 98% b.p. 64 °C |
| 3-Dimethylamino-1-propyne |  | liquid assay 97% b.p. 81 °C |
| Diallyl-dimethylamonium chloride |  | 65 wt.% in H2O |
| Anchored Compounds | ||
| 4-Chloro-2-isopropyl-5- methylphenol |  | crystals assay 99% ethanol: soluble 10% |
| 3,5-Dichlorophenol (DCP) |  | crystals assay 97% ethanol: very soluble |
| 2-Isopropyl-5-methylphenol (Thymol) |  | crystals assay ≥ 98.5% ethanol: soluble 5% |
| 5-Chloro-2-(2,4-dichlorophenoxy) phenol (Triclosan) (TCS) |  | crystals assay 99% ethanol: very soluble |
| Diameter * of The Growth Inhibition Zones [mm] | ||||||||
|---|---|---|---|---|---|---|---|---|
| Mold Fungi Species → | A. niger | A. fumigatus | A. tenuissima | P. chrysogenum | ||||
| Precursor concentration [mol/L]→ | 0.01 | 0.1 | 0.01 | 0.1 | 0.01 | 0.1 | 0.01 | 0.1 |
| Incubation time [h]→ | 24 | 24 | 24 | 24 | 72 | 72 | 72 | 72 |
| Precursor type ↓ | ||||||||
| 2-Allylphenol (APh) | 18 | 50 | 10 | 41 | 10 | 56 | 0 | 40 |
| 2-Methoxy-4-(2-propenyl)phenol (Eugenol) | 14 | 43 | 13 | 33 | 10 | 60 | 10 | 37 |
| Allylamine (AA) | 0 | 0 | 0 | 0 | 0 | 0 | 0 | 0 |
| N,N-Dimethylallylamine (DMAA) | 8 | 35 | 7 | 27 | 17 | 47 | 0 | 34 |
| 3-Dimethylamino-1-propyne | 8 | 16 | 0 | 7 | 10 | 14 | 0 | 10 |
| Diallyl-dimethylamonium chloride | 0 | 0 | 0 | 0 | 0 | 0 | 0 | 0 |
| 4-Chloro-2-isopropyl-5-methyl-phenol | 12 | 28 | 13 | 32 | 18 | 49 | 7 | 15 |
| 3,5-Dichlorophenol (DCP) | 26 | 52 | 18 | 58 | 49 | 82 | 33 | 72 |
| 2-Isopropyl-5-methyl- phenol (Thymol) | 16 | 62 | 14 | 49 | 14 | 49 | 0 | 22 |
| 5-Chloro-2-(2,4-dichlorophenoxy) phenol (Triclosan) (TCS) | 20 | 22 | 22 | 23 | 42 | 44 | 38 | 40 |
Publisher’s Note: MDPI stays neutral with regard to jurisdictional claims in published maps and institutional affiliations. |
© 2022 by the authors. Licensee MDPI, Basel, Switzerland. This article is an open access article distributed under the terms and conditions of the Creative Commons Attribution (CC BY) license (https://creativecommons.org/licenses/by/4.0/).
Share and Cite
Tyczkowska-Sieroń, E.; Kiryszewska-Jesionek, A.; Kapica, R.; Tyczkowski, J. Anti-Mold Protection of Textile Surfaces with Cold Plasma Produced Biocidal Nanocoatings. Materials 2022, 15, 6834. https://doi.org/10.3390/ma15196834
Tyczkowska-Sieroń E, Kiryszewska-Jesionek A, Kapica R, Tyczkowski J. Anti-Mold Protection of Textile Surfaces with Cold Plasma Produced Biocidal Nanocoatings. Materials. 2022; 15(19):6834. https://doi.org/10.3390/ma15196834
Chicago/Turabian StyleTyczkowska-Sieroń, Ewa, Agnieszka Kiryszewska-Jesionek, Ryszard Kapica, and Jacek Tyczkowski. 2022. "Anti-Mold Protection of Textile Surfaces with Cold Plasma Produced Biocidal Nanocoatings" Materials 15, no. 19: 6834. https://doi.org/10.3390/ma15196834
APA StyleTyczkowska-Sieroń, E., Kiryszewska-Jesionek, A., Kapica, R., & Tyczkowski, J. (2022). Anti-Mold Protection of Textile Surfaces with Cold Plasma Produced Biocidal Nanocoatings. Materials, 15(19), 6834. https://doi.org/10.3390/ma15196834









